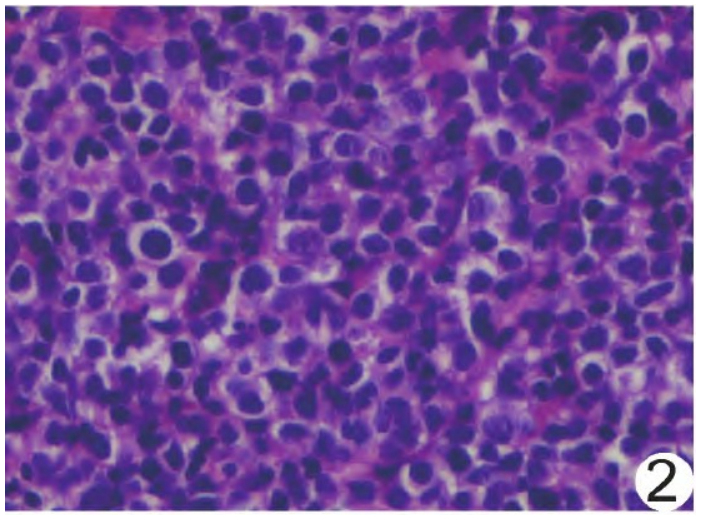

1例超声心动图观察转移性右心弥漫大B细胞淋巴瘤表现
作者:唐华,北京高博博仁医院超声室
患者男,54岁,发现双侧大腿前内侧肿物伴压痛1周;患胃弥漫大B细胞淋巴瘤 (diffuse large B-cell lymphoma, DLBCL)1年余,经外院化学治疗(化疗)效果不佳。查体:慢性病容,全身浅表区触及多发轻度肿大淋巴结。
(diffuse large B-cell lymphoma, DLBCL)1年余,经外院化学治疗(化疗)效果不佳。查体:慢性病容,全身浅表区触及多发轻度肿大淋巴结。
实验室检查:淋巴细胞计数0.68×109/L,血红蛋白 109 g/L,血小板计数103×109/L,乳酸脱氢酶375.00 U/L,C反应蛋白20.17 mg/L。超声心动图
109 g/L,血小板计数103×109/L,乳酸脱氢酶375.00 U/L,C反应蛋白20.17 mg/L。超声心动图 :右心内82 mm×48 mm形态不规则中等偏低回声占位横跨三尖瓣(图1A),与右房室壁分界不清,活动度小;双侧股四头肌内低回声肿物,结合病史考虑为淋巴瘤转移。PET/CT:右侧胸膜及双肺内见结节,心脏肿瘤,多发肌肉占位,均伴代谢增高;考虑淋巴瘤多部位浸润。
:右心内82 mm×48 mm形态不规则中等偏低回声占位横跨三尖瓣(图1A),与右房室壁分界不清,活动度小;双侧股四头肌内低回声肿物,结合病史考虑为淋巴瘤转移。PET/CT:右侧胸膜及双肺内见结节,心脏肿瘤,多发肌肉占位,均伴代谢增高;考虑淋巴瘤多部位浸润。
行左大腿肿物穿刺活检术;病理:光镜下见中等偏大的肿瘤细胞弥漫增生浸润,细胞质淡染,核类圆或不规则,核仁不明显(图2),免疫组织化学显示Bc1-2(约90%+)、Bcl-6(+)、CD5(-)、CD10(-)、CD19(70%弱+)、CD20(90%+)、CD22(90%+)、CD30(-)、CD79a(90%+)、C-myc(20%+)、Ki-67(90%+)、MUM1(+)、P53(15%+),原位杂交示EBERs(-),诊断为(左大腿)DLBCL。
最终临床诊断:胃DLBCL全身转移。化疗1周后超声示右心肿瘤缩小至71 mm×36 mm(图1B),双大腿肿块缩小;4周后右心肿瘤缩小至22 mm×17 mm, 呈高回声,三尖瓣启闭恢复正常(图1C),双大腿肿块消失;11周后右心高回声缩小至7 mm×7 mm(图1D)。本例报道经医院伦理委员会免除伦理审查。

图1 转移性右心DLBCL超声心动图。A.入院后;B.化疗1周后;C.化疗4周后;D.化疗11周后(M:肿物)
图2右心弥漫大B细胞淋巴瘤病理图(HE,×400)
讨论
DLBCL是成人常见非霍奇金恶性淋巴瘤 ,结外以胃肠多见,心腔内出现概率极小。心脏淋巴瘤可呈结节状或球状向心腔内生长而致心脏压塞
,结外以胃肠多见,心腔内出现概率极小。心脏淋巴瘤可呈结节状或球状向心腔内生长而致心脏压塞 ,亦可在心肌内浸润性生长形成结节或不规则肿块,造成阶段性室壁运动异常,侵犯心包膜可致心包积液,少数可侵犯心脏邻近大血管。
,亦可在心肌内浸润性生长形成结节或不规则肿块,造成阶段性室壁运动异常,侵犯心包膜可致心包积液,少数可侵犯心脏邻近大血管。
本例病史及左大腿肿块活检结果明确,诊断为胃DLBCL全身转移;化疗后右心肿瘤迅速缩小,支持右心肿物为转移性DLBCL。本例心脏病 变具有较典型的淋巴瘤表现,有助于与心脏原发性黏液瘤相鉴别。黏液瘤多位于左心房,以细蒂连于房间隔,活动度较大,边界清,无心肌浸润等恶性表现。超声心动图可为诊断 DLBCL累及心脏及评估其对化疗的反应提供及时、可靠的信息。
变具有较典型的淋巴瘤表现,有助于与心脏原发性黏液瘤相鉴别。黏液瘤多位于左心房,以细蒂连于房间隔,活动度较大,边界清,无心肌浸润等恶性表现。超声心动图可为诊断 DLBCL累及心脏及评估其对化疗的反应提供及时、可靠的信息。
来源:唐华.1例超声心动图观察转移性右心弥漫大B细胞淋巴瘤表现[J].中国医学影像技术,2024,40(03):468.
